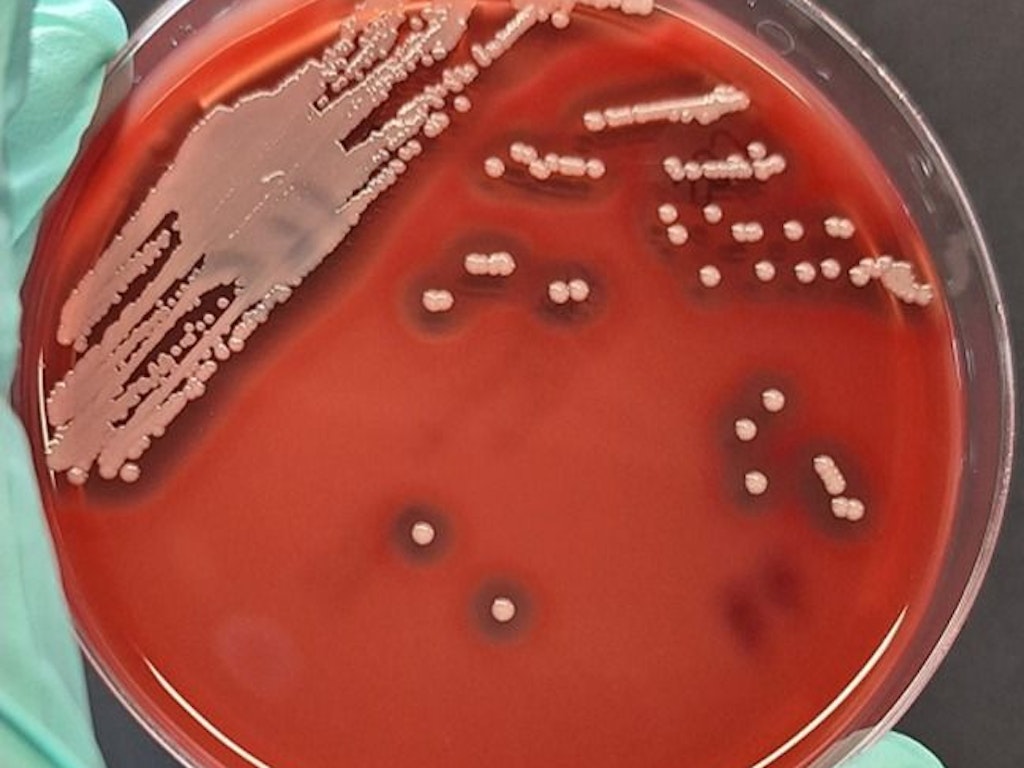

Bekämpfung von Antibiotikaresistenzen
Zur Reduktion von Antibiotikaresistenzen werden Massnahmen getroffen, um die Übertragung und Verbreitung von resistenten Bakterien einzuschränken.

News
Einhaltung der nationalen MRE-Richtlinien in Schweizer Spitälern
10.11.2025 - Wie gut halten sich Schweizer Spitäler an die nationalen Empfehlungen zur Verhinderung der Ausbreitung multiresistenter Erreger (MRE)? Eine kürzlich von Swissnoso durchgeführte Studie bewertete die Screening-Praktiken in Akutspitälern und untersuchte mögliche Lücken bei der Umsetzung der Richtlinien. Die Studie liefert wertvolle Erkenntnisse über die Herausforderungen und Möglichkeiten zur Verbesserung der Infektionskontrolle in Schweizer Spitälern. Die Einhaltung der Richtlinien für das Aufnahme-Screening lag für fünf MRE bei insgesamt 69 %. Die Nichteinhaltung durch das Gesundheitspersonal wurde als das grösste Hindernis für die Umsetzung der Richtlinien identifiziert.
Multiresistente Erreger unter Kontrolle halten
05/2022 - In den letzten zwei Jahren hat SARS-CoV-2 die Gesundheitseinrichtungen geprägt. Andere Herausforderungen wie die Prävention und Kontrolle von multiresistenten Erregern (MRE) und die Überwachung neu auftretender Erreger wie Candida auris rückten in den Hintergrund. Kürzlich hat Swissnoso zu diesen Themen neue Richtlinien zuhanden der Spitäler publiziert.
Einschleppung und Ausbreitung von resistenten Erregern verhindern
Resistente Erreger können von Patientinnen und Patienten in eine Gesundheitseinrichtung eingeschleppt werden. Beispielsweise erhöhen Auslandsreisen und der beruflich bedingte Kontakt mit Erregern das Risiko, Träger von resistenten Erregern zu sein. Wenn Patientinnen und Patienten, die resistente Erreger in sich tragen, bereits beim Eintritt in eine Gesundheitseinrichtung durch ein Screening identifiziert werden, kann die Ausbreitung der Resistenz leichter eingedämmt werden. Um die Screening-Praktiken zu vereinheitlichen, die Lücken zu schliessen und so die Verbreitung resistenter Erreger im Krankenhausbereich einzudämmen, hat Swissnoso 2021 im Rahmen von StAR nationale Richtlinien zur Prävention und Kontrolle von multiresistenten Erregern (MRE) im Nicht-Ausbruch-Setting ausgearbeitet. Diese enthalten erregerspezifische Empfehlungen zum systematischen Screening und zu gezielten präventiven Massnahmen.
Eine 2023 durchgeführte nationale Umfrage in den Spitälern zeigt, dass beim MRE-Screening im Vergleich zu einer ersten Erhebung im Jahr 2018 Fortschritte gemacht wurden. Während Eintritts-Screenings von im Ausland hospitalisierten Reisenden in den meisten Spitälern durchgeführt werden, besteht noch Verbesserungspotential bei der Aufnahme von Patienten, die aus Schweizer Gesundheitseinrichtungen mit anhaltenden Ausbrüchen mit MRE verlegt wurden, sowie bei der aktiven Überwachung z.B. mittels wöchentlicher MRE-Screenings auf Abteilungen mit schwer kranken und immungeschwächten Patienten. Zudem führen vor allem kleine Spitäler selten Screenings auf Candida auris durch, ein oft resistenter Erreger schwerer Pilzinfektionen der sich weltweit rasch verbreitet.
Ausbrüche von resistenten Erregern gezielt bekämpfen
Wenn es in einer Gesundheitseinrichtung zu einem Ausbruch von Infektionsfällen durch einen resistenten Erreger kommt, müssen systematisierte Abläufe den Patientenschutz und die Eindämmung der Ausbreitung gewährleisten.
Wenn es in einer Gesundheitseinrichtung zum Ausbruch eines resistenten Erregers kommt, muss das Personal rasch und gemäss einem klar definierten Ablauf handeln. Zur Vereinheitlichung dieser Abläufe wurden nationale Richtlinien zum Management von Ausbrüchen mit MRE erarbeitet. Diese enthalten Empfehlungen für konkrete Massnahmen und Schritte, welche im Falle eines Ausbruchs einzuleiten sind. Sie ermöglichen so den Schutz der Risikopatientinnen und Risikopatienten sowie des Personals und verhindern eine weitere Ausbreitung.
Weitere Informationen
Inhaltsverzeichnis
zurück zur Übersicht "Antibiotikaresistenzen Bereich Mensch"
Weiterführende Themen
Strategie NOSO: Spital- und Pflegeheiminfektionen reduzieren
Melden Sie sich zum Webinar am 3. Dezember 2026 zur Umsetzung der strukturellen Mindestanforderungen und der operativen Ziele in Schweizer Akutspitälern an!
Bundesamt für Gesundheit BAG
Sektion Infektionskontrolle und Bekämpfungsmassnahmen
Schwarzenburgstrasse 157
Schweiz - 3003 Bern